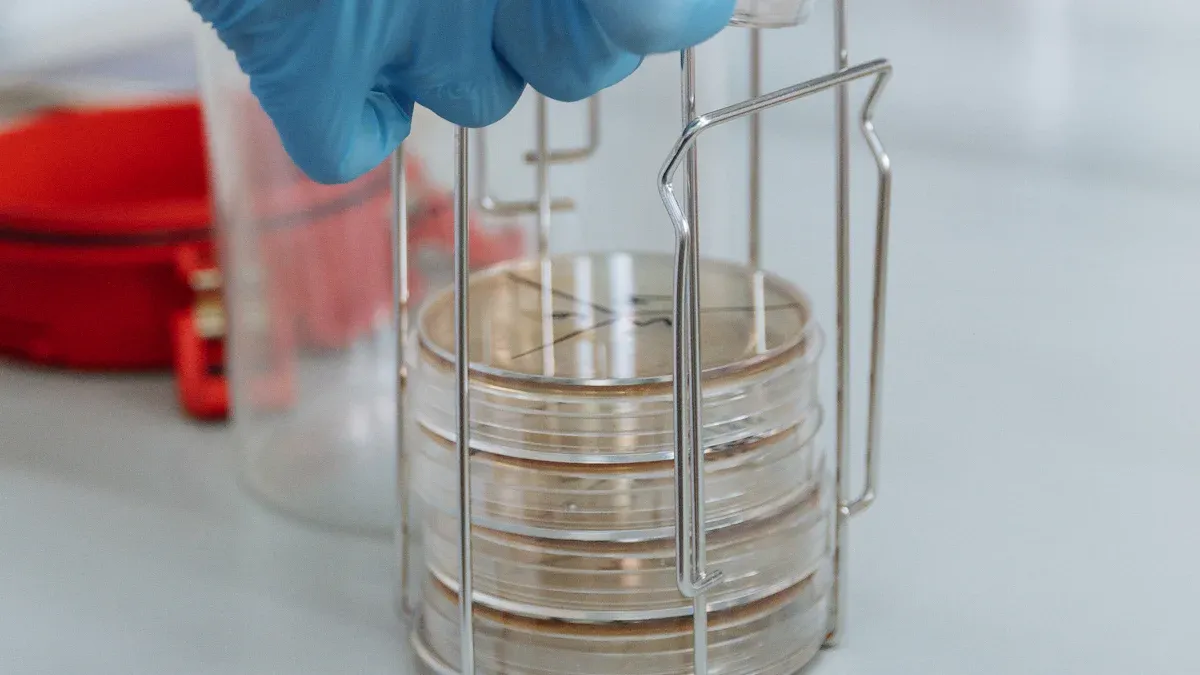
Part 4: Implementation and Testing

You depend on analytical balances to deliver precise measurements. Battery noise can disrupt this accuracy, especially in environments that demand low noise levels. When you use lithium battery packs, you benefit from lower noise compared to switching power supplies. These battery systems avoid the 60Hz hum that often interferes with sensitive equipment. Low-noise batteries play a crucial role in minimizing interference. Advanced design strategies help you control noise and maintain low noise for high-precision results. By understanding battery noise and choosing low-noise solutions, you can optimize your measurement systems for reliability.
Key Takeaways
Choose lithium battery chemistries like LiFePO4 or NMC for low noise and high safety in analytical balances.
Optimize circuit design and use extensive ground planes to minimize noise in battery management systems.
Integrate low-noise regulators and amplifiers to maintain signal quality and reduce interference.
Test battery packs using high-frequency acoustic methods to detect noise and ensure reliable performance.
Implement active cell balancing to enhance battery efficiency and reduce noise in sensitive applications.
Part 1: Battery Noise and Its Impact

1.1 Types of Noise
You encounter several types of noise when working with lithium-ion batteries in analytical balances. Electrical noise includes random fluctuations in voltage and current. You see this as thermal noise, shot noise, and flicker noise. Thermal noise comes from the movement of electrons inside the battery. Shot noise appears due to the discrete nature of charge carriers. Flicker noise, also called 1/f noise, increases at lower frequencies. You also face electromagnetic interference, which can enter the system from external sources. Mechanical noise, such as vibrations, can affect the balance readings. You must recognize these types of noise to design effective solutions for lithium-ion batteries.
Tip: You can reduce noise by using shielded cables and placing the balance away from sources of electromagnetic interference.
1.2 Effects on Measurement Accuracy
Noise can disrupt the accuracy of your analytical balances. When lithium-ion batteries generate noise, you may see unstable readings and drifting measurements. Even small amounts of noise can cause significant errors in high-precision environments. You must control noise to ensure repeatable and reliable results. Environmental factors also play a role. Temperature changes can increase battery noise and affect weighing accuracy. High humidity can cause samples to absorb moisture, leading to incorrect readings. Air currents and vibrations from nearby equipment can introduce additional noise. You should maintain a stable temperature and humidity, position the balance away from drafts, and isolate it from vibrations.
Maintain controlled temperature and humidity with HVAC systems.
Place the balance away from air conditioning vents and drafts.
Use anti-static materials and ground all components to prevent static buildup.
Isolate the balance from vibrations by using a stable surface.
1.3 Sources in Lithium Battery Packs
Lithium-ion batteries in laboratory equipment have several sources of noise. Cooling systems, such as fans and pumps, create airflow noise. Inverters produce noise during DC to AC conversion, often at specific frequencies. Transformers generate a hum due to electromagnetic forces in their core and coils. You must consider these sources when designing lithium-ion battery packs for analytical balances. You can minimize noise by selecting low-noise components and optimizing the layout of the battery pack. You should use LiFePO4, NMC, LCO or LMO chemistries for their stable performance and lower noise profiles. You can further reduce noise by using shielded enclosures and proper grounding techniques.
Cooling systems: Airflow vents, fans, and pumps.
Inverters: Tonal sounds during DC to AC conversion.
Transformers: Hum from core, coil, and fan noise.
Note: You should keep lithium-ion batteries away from motors and transformers to avoid additional noise.
Part 2: Design Principles for Low-Noise Batteries
Designing low-noise batteries for high-precision analytical balances requires you to focus on every detail of the battery management system. You must understand how each design choice affects noise and how to achieve low noise in your battery-powered devices. This section guides you through the most effective strategies for minimizing noise and ensuring reliable performance.
2.1 Circuit Design and Ground Plane
You start by optimizing your circuit design. Accurate signal conditioning is essential for high-resolution measurements in analytical balances. The noise floor of your system sets the limit for measurement accuracy. You must keep this noise as low as possible.
Use careful routing of PCB traces to prevent unwanted noise coupling.
Employ extensive ground plane areas in your battery management system. Ground planes provide a low-impedance path for return currents, which helps reduce noise in your battery circuits.
Bypass power distribution lines for gas gauge and related ICs to prevent noise from spreading.
Make solid connections between the gas-gauge IC and the current-measurement shunt to avoid introducing extra noise.
Ground planes also act as shields against electromagnetic interference (EMI) and radio frequency interference (RFI). This shielding is crucial for precision measurement devices. By maintaining stable signal references, ground planes help you achieve low noise and high signal integrity.
Tip: Always calculate the overall noise of your analog front-end. Understanding component-level noise sources lets you minimize system noise in your battery-powered analytical balances.
2.2 Low-Dropout Regulators (LDOs)
Low-dropout regulators play a key role in reducing noise in your battery management system. LDOs stabilize the voltage supplied to sensitive analog circuits, which helps you achieve low noise operation. Not all LDOs perform the same, so you must choose the right type for your application.
LDO Type | Output Noise | Application Suitability |
|---|---|---|
LDO A | Ultra-low | Sensitive analog circuits |
LDO B | Low | RF devices |
LDO C | Moderate | General applications |
You should select ultra-low noise LDOs for the analog front-end of your analytical balances. These LDOs help you maintain the low noise required for high-precision measurements. Always check the output noise specification of the LDO before integrating it into your battery management system.
2.3 Low-Noise Amplifiers
Low-noise amplifiers are essential for boosting weak signals without adding significant noise. You need these amplifiers in your battery-powered analytical balances to ensure that the signal from the load cell or sensor remains clean. Choose amplifiers with a low input-referred noise specification. This choice helps you keep the overall noise floor of your system as low as possible.
Place low-noise amplifiers close to the sensor to minimize noise pickup.
Use proper PCB layout techniques to separate analog and digital sections.
Shield amplifier circuits from external noise sources.
You must also consider the power supply for your amplifiers. Using a dedicated low-noise LDO for the amplifier can further reduce noise in your battery management system.
2.4 Shielding Techniques
Shielding protects your battery management system from external and internal sources of noise. You can use both active and passive shielding methods to achieve low noise in your analytical balances.
Technique | Description |
|---|---|
Anti-Interference Designs | Select balances with designs that resist interference for better reliability. |
Shock-Absorbing Structures | Use suspended structures to reduce vibration impact. |
Air Flow Compensation | Employ intelligent systems to offset air disturbances automatically. |
Multi-Layer Electromagnetic Shielding | Use circuit designs that resist external electromagnetic interference. |
Active shielding targets the source of interference within your battery system, preventing it from radiating noise.
Passive shielding protects sensitive equipment from external electromagnetic interference.
Shielding acts as a metal barrier between two areas, blocking the propagation of electromagnetic energy. This approach reduces EMI by interrupting the coupling paths. You must use both active and passive shielding to maintain the integrity of your low-noise batteries in laboratory environments.
Note: Always combine shielding with good circuit design and grounding practices. This combination gives you the best chance of achieving low noise in your battery-powered analytical balances.
Part 3: Battery Selection and Materials
3.1 Low-Noise Battery Chemistries
You need to select the right battery chemistry to achieve low noise in high-precision analytical balances. Lithium battery packs offer several options. LiFePO4, NMC, LCO, LMO, and LTO each have unique properties that affect noise and battery performance. LiFePO4 provides a platform voltage of 3.2V, energy density of 90–120 Wh/kg, and a cycle life of 2000–7000 cycles. NMC offers 3.7V, 150–220 Wh/kg, and 1000–2000 cycles. LCO gives 3.7V, 150–200 Wh/kg, and 500–1000 cycles. LMO delivers 3.7V, 100–150 Wh/kg, and 300–700 cycles. LTO stands out with 2.4V, 70–80 Wh/kg, and over 7000 cycles. You should choose LiFePO4 or LTO for low noise and high safety. These chemistries show stable battery technology and low noise output, which is critical for analytical balances.
Tip: Always match the battery chemistry to your application’s noise and safety requirements.
3.2 Electrode and Separator Materials
You can further reduce noise by selecting the right electrode and separator materials. High-purity graphite and lithium iron phosphate electrodes help minimize electrical noise. Ceramic-coated separators improve insulation and lower the risk of internal shorts, which supports safety and low noise. You should avoid materials that degrade quickly or generate excess heat, as these can increase noise and reduce battery performance. Consistent material quality ensures stable battery technology and reliable low noise operation.
Use high-purity graphite for the anode.
Select LiFePO4 or LTO for the cathode.
Choose ceramic-coated separators for added safety and low noise.
3.3 Proven Configurations
You achieve the best results by using proven battery configurations. Multi-cell lithium battery packs with integrated battery management systems (BMS) help control noise and maintain safety. Shielded enclosures and balanced cell layouts further reduce noise. You should test each configuration for low noise before deployment. Reliable battery technology and careful design ensure your analytical balances deliver accurate results with minimal noise.
Chemistry | Platform Voltage | Energy Density (Wh/kg) | Cycle Life | Low Noise | Safety |
|---|---|---|---|---|---|
LiFePO4 | 3.2V | 90–120 | 2000–7000 | Yes | High |
NMC | 3.7V | 150–220 | 1000–2000 | Moderate | High |
LCO | 3.7V | 150–200 | 500–1000 | Moderate | Medium |
LMO | 3.7V | 100–150 | 300–700 | Moderate | Medium |
LTO | 2.4V | 70–80 | 7000+ | Yes | High |
Note: Always verify battery technology and configuration in your lab environment to ensure low noise and safety.
Part 4: Implementation and Testing
4.1 Integration Steps
You need a structured approach when integrating lithium battery packs into high-precision analytical balances. Start by selecting the correct battery chemistry, such as LiFePO4 or LTO, to ensure low noise and high safety. Prepare your battery management system (BMS) with a focus on cell balancing. Place the battery pack in a shielded enclosure to minimize noise from external sources. Connect the power supply lines using short, shielded cables to reduce electromagnetic interference.
Follow these steps for successful integration:
Choose the battery chemistry (LiFePO4, NMC, LCO, LMO, LTO) based on platform voltage, energy density, and cycle life.
Assemble the battery pack with a BMS that supports active cell balancing.
Install the battery pack in a location away from motors and transformers to avoid noise.
Connect the power supply to the analytical balance, ensuring all ground connections are secure.
Test the system for noise using both electrical and acoustic methods.
Adjust the control algorithm in the BMS to optimize cell balancing and balancing efficiency.
Monitor the battery performance and noise levels during operation.
Tip: Always document each integration step. This practice helps you identify the source of noise if issues arise later.
4.2 High-Frequency Acoustic Wave Testing
You can use high-frequency acoustic wave testing to detect noise in lithium battery packs. This method helps you identify problems that electrical testing might miss. Two main techniques stand out for laboratory balances:
Ultrasonic Testing (UT): This non-invasive method uses high-frequency sound waves to probe the battery. UT can reveal changes in the state of charge and detect internal defects. You gain insights into the health and structural integrity of the battery.
Acoustic Emission (AE): AE captures stress waves produced by structural changes inside the battery. This technique helps you monitor battery health and detect early signs of degradation.
Both UT and AE provide valuable data without damaging the battery. You can use these methods to ensure your battery packs maintain low noise and reliable performance.
Note: High-frequency acoustic wave testing works best when combined with electrical noise measurements. This combination gives you a complete picture of battery health.
4.3 Current Measurement Devices
You need accurate current measurement devices to monitor the performance of your lithium battery packs. These devices help you detect noise and verify the effectiveness of cell balancing. Use precision shunt resistors and low-noise amplifiers to measure current flow. Place the measurement devices close to the battery pack to reduce noise pickup.
Consider these options for current measurement:
Hall-effect sensors: These sensors provide contactless current measurement and minimize noise introduction.
Precision shunt resistors: Use these with low-noise amplifiers for high-accuracy readings.
Digital current monitors: These devices offer real-time data and can interface with your control algorithm for active cell balancing.
You should calibrate your current measurement devices regularly. This practice ensures accurate readings and helps you maintain low noise in your analytical balances.
4.4 Active Cell Balancing
You must implement active cell balancing to achieve optimal performance in lithium battery packs. This process redistributes energy between cells, ensuring each cell maintains the same state of charge. Active cell balancing improves balancing efficiency and extends battery life. You need a robust control algorithm to manage the cell balancing process.
Active cell balancing works by transferring energy from higher-charged cells to lower-charged ones. This method reduces noise caused by voltage imbalances and prevents overcharging or deep discharging. You should select a BMS that supports active cell balancing and allows you to adjust the control algorithm for your specific application.
Key benefits of active cell balancing include:
Improved balancing efficiency
Reduced noise in noise-sensitive circuitry
Enhanced battery safety and longevity
You should monitor the cell balancing process continuously. Use data from current measurement devices and acoustic wave testing to fine-tune the control algorithm. This approach ensures your battery packs deliver low noise and stable performance in analytical balances.
Callout: Active cell balancing is essential for maintaining low noise and high balancing efficiency in lithium battery packs used in laboratory environments.
4.5 Troubleshooting Noise Issues
You may encounter noise issues even after careful integration. Start troubleshooting by isolating the source of noise. Check all connections and grounding points. Use both electrical and acoustic testing methods to pinpoint the problem.
Follow this troubleshooting checklist:
Inspect the battery pack for loose connections or damaged components.
Verify the operation of the BMS and the active cell balancing function.
Test the power supply for voltage fluctuations or ripple.
Use ultrasonic testing and acoustic emission techniques to detect internal battery noise.
Review the control algorithm settings for cell balancing and balancing efficiency.
Replace any faulty components and retest the system.
You should keep detailed records of all troubleshooting steps. This documentation helps you identify recurring noise issues and refine your integration process.
Tip: Regular maintenance and testing prevent most noise problems in lithium battery packs. Schedule routine checks for cell balancing, power supply stability, and battery health.
You improve measurement accuracy in analytical balances by designing and implementing low-noise battery systems. You start by selecting the right lithium battery chemistry, such as LiFePO4, NMC, LCO, LMO, or LTO, and use high-quality electrode and separator materials. You optimize battery circuit design, ground planes, and shielding to reduce battery noise. You integrate low-dropout regulators and low-noise amplifiers to maintain battery signal quality. You test battery packs using high-frequency acoustic wave methods and current measurement devices. You apply active cell balancing to keep battery performance stable. You use techniques like averaging ADC readings, low-pass filters, and noise-shaping methods to further reduce battery noise. You monitor battery systems and adjust your approach for ongoing optimization. You see that noise reduction in battery systems leads to better signal quality, more reliable modeling, and improved parameter estimation. You avoid distorted impedance spectra and incorrect interpretations by maintaining low battery noise. You use advanced methods, such as discrete wavelet transforms and machine learning, to denoise battery data and enhance measurement efficiency. You balance noise reduction with resolution, bandwidth, and power consumption in battery-powered analytical balances. You continue to test and refine battery systems to ensure reliable performance.
Select lithium battery chemistry and materials for low noise.
Optimize battery circuit design and shielding.
Integrate low-noise regulators and amplifiers.
Test battery packs with acoustic and electrical methods.
Apply active cell balancing and ongoing optimization.
Tip: You achieve the highest measurement accuracy by maintaining low battery noise and regularly testing your battery systems.
FAQ
What lithium battery chemistry offers the lowest noise for analytical balances?
LiFePO4 and LTO chemistries provide the lowest noise. LiFePO4 delivers 3.2V, 90–120 Wh/kg, and 2000–7000 cycles. LTO offers 2.4V, 70–80 Wh/kg, and over 7000 cycles. You achieve stable performance and high safety with these options.
How does active cell balancing improve battery performance?
Active cell balancing redistributes energy between cells. You maintain equal charge levels, reduce noise, and extend battery life. This process helps you avoid voltage imbalances and supports reliable operation in high-precision environments.
Which shielding technique works best for lithium battery packs?
Multi-layer electromagnetic shielding blocks external interference. You protect sensitive circuits and maintain low noise. Combine shielding with proper grounding and layout for the best results in analytical balances.
Why should you use ceramic-coated separators in lithium battery packs?
Ceramic-coated separators improve insulation and safety. You lower the risk of internal shorts and reduce electrical noise. This choice supports stable operation and enhances the reliability of your analytical balances.
What is the recommended method for testing battery noise?
You should use high-frequency acoustic wave testing, such as ultrasonic testing and acoustic emission. These methods help you detect internal defects and monitor battery health. Combine acoustic tests with electrical measurements for a complete analysis.

